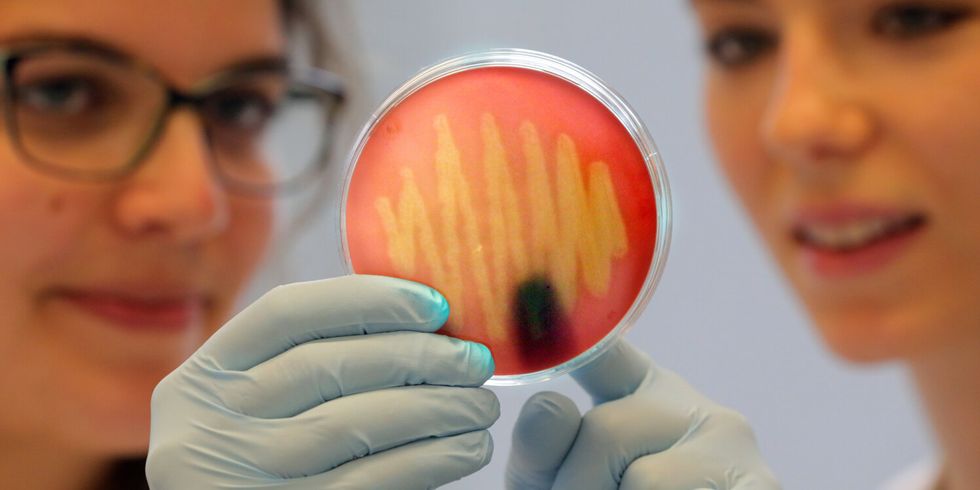
Gesundheitswesen

Der überarbeitete Masterplan Gesundheitsregion Berlin-Brandenburg (PDF), der 2014 verabschiedet wurde, ist die strategische Grundlage für die Umsetzung der länderübergreifenden Aktivitäten.
Der Masterplan definiert strategische Ziele, thematische Schwerpunkte und Maßnahmen und gliedert sich in vier Handlungsfelder:
- Biotechnologie & Pharma
- Medizintechnik
- Neue Versorgungsformen & Rehabilitation
- Gesundheitsförderung, Prävention & Gesundheitstourismus
Handlungsfeldübergreifend werden fünf zentrale Themen als sogenannte Integrativthemen entwickelt:
- Fachkräfte
- Ansiedlung & Bestandsentwicklung
- Internationalisierung
- E-Health
- Alternde Gesellschaft
Mehr Informationen zu Struktur und Aufbau des Clusters, zu Aktivitäten, Terminen und Neuigkeiten in der Gesundheitsregion, zu Fördermöglichkeiten, Ansprechpartnerinnen und Ansprechpartnern sowie Informationsbroschüren zu gesundheitsbezogenen Ausbildungs- und Studiengängen, zu Rehabilitationsangeboten etc. finden Sie auf den Seiten von HealthCapital Berlin-Brandenburg (Startseite HealthCapital Berlin-Brandenburg)”:http://www.healthcapital.de/.